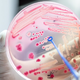
Ko blago vnetje sečil skoraj povzroči smrt: kako hitro se lahko razvije življenjsko nevarna sepsa

Strokovnjaki iščejo tudi vse tesne stike obolelih in jim preventivno zagotavljajo antibiotike, da bi omejili širjenje bolezni. V južni Angliji je izbruhnila nevarna oblika meningitisa in sepse. Umrla sta dva … · Žurnal24 · 2t

CRP je eden najpogostejših krvnih testov. Povišana vrednost lahko pomeni okužbo, vnetje ali resnejšo bolezen. Kaj pravzaprav sporoča ta izvid? Ko zdravnik naroči krvne preiskave, se med izvidi pogosto pojavi … · Svet24 · 4t

Mia je bila stara sedem mesecev in pol, ko je zbolela za meningokokno sepso tipa B. Mati Monika opozarja, da jima s soprogom nihče ni povedal za možnost cepljenja, ki … · Večer · 1M

31-letni Jan Maletič se je rodil z zaporo črevesja in ima danes – zaradi popolne odpovedi prebavil – le še 50 centimetrov tankega črevesa in 15 centimetrov debelega. Že od … · 24ur · 1M
infuzija jan maletič paranteralna hrana prebavila objavi tvitaj
Blago vnetje sečil se lahko v redkih primerih razvije v hudo okužbo, ki ogrozi življenje, če je ne prepoznate pravočasno. Kot navaja Daily Mail , se lahko navidezno nenevarna okužba … · Vizita.si · 1M
življenjske zgodbe okužba vnetje sečil zdravje simptomi sepsa objavi tvitaj

Bralka je potožila, da je njen bolni sorodnik po vsaki operaciji zaradi okužb v večjih težavah. Ali higiena v bolnišnicah šepa? »Sorodnik je bil sorodnik večkrat operiran, komplikacij in zapletov … · Svet24 · 2M

Šest primerov: Zavarovalnice razkrile, ali bi denar povrnile ali ne Pred kratkim smo poročali o dveh primerih, ko zavarovalnici nista povrnili stroškov zdravljenja v tujini, saj je po njuni oceni … · Žurnal24 · 2M
zdravstveno zavarovanje coris zavarovalnice triglav vzajemna zavarovanje za tujino objavi tvitaj